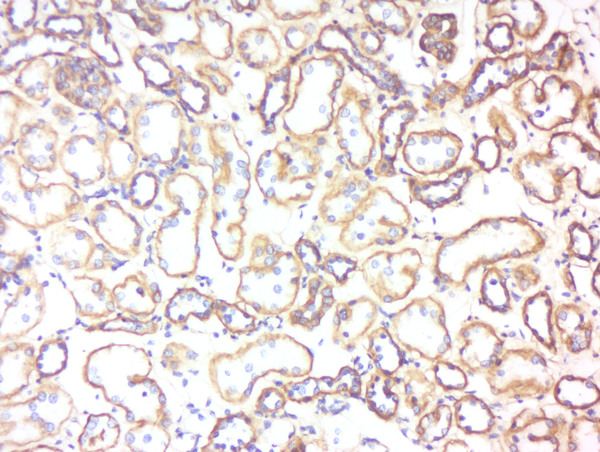
Formalin-fixed and paraffin embedded human kidney labeled with Rabbit Anti-5HT3B receptor Polyclonal Antibody, Unconjugated (bs-4289R) at 1:200 followed by conjugation to the secondary antibody and DAB staining Formalin-fixed and paraffin embedded human kidney labeled with Rabbit Anti-5HT3B receptor Polyclonal Antibody, Unconjugated (bs-4289R) at 1:200 followed by conjugation to the secondary antibody and DAB staining

LoVo cell lysates probed with 5HT3B receptor Polyclonal Antibody, Unconjugated (bs-4289R) at 1:300 dilution and 4˚C overnight incubation. Followed by conjugated secondary antibody incubation at 1:20000 for 60 min at 37˚C.
5HT3B receptor Polyclonal Antibody
BS-4289R
ApplicationsFlow Cytometry, ImmunoFluorescence, Western Blot, ELISA, ImmunoCytoChemistry, ImmunoHistoChemistry, ImmunoHistoChemistry Frozen, ImmunoHistoChemistry Paraffin
Product group Antibodies
TargetHTR3B
Overview
- SupplierBioss
- Product Name5HT3B receptor Polyclonal Antibody
- Delivery Days Customer16
- ApplicationsFlow Cytometry, ImmunoFluorescence, Western Blot, ELISA, ImmunoCytoChemistry, ImmunoHistoChemistry, ImmunoHistoChemistry Frozen, ImmunoHistoChemistry Paraffin
- Applications SupplierWB(1:300-5000), ELISA(1:500-1000), FCM(1:20-100), IHC-P(1:200-400), IHC-F(1:100-500), IF(IHC-P)(1:50-200), IF(IHC-F)(1:50-200), IF(ICC)(1:50-200)
- CertificationResearch Use Only
- ClonalityPolyclonal
- Concentration1 ug/ul
- ConjugateUnconjugated
- Gene ID9177
- Target nameHTR3B
- Target description5-hydroxytryptamine receptor 3B
- Target synonyms5-HT3B, 5-hydroxytryptamine receptor 3B, 5-hydroxytryptamine (serotonin) receptor 3B, ionotropic, 5-hydroxytryptamine 3 receptor B subunit, serotonin-gated ion channel subunit
- HostRabbit
- IsotypeIgG
- Storage Instruction-20°C
- UNSPSC12352203